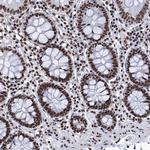
UBA2 Antibody in Immunohistochemistry (Paraffin) (IHC (P))

Search
Invitrogen
UBA2 Polyclonal Antibody
{{$productOrderCtrl.translations['antibody.pdp.commerceCard.promotion.promotions']}}
{{$productOrderCtrl.translations['antibody.pdp.commerceCard.promotion.viewpromo']}}
{{$productOrderCtrl.translations['antibody.pdp.commerceCard.promotion.promocode']}}: {{promo.promoCode}} {{promo.promoTitle}} {{promo.promoDescription}}. {{$productOrderCtrl.translations['antibody.pdp.commerceCard.promotion.learnmore']}}
产品信息
PA5-83556
种属反应
宿主/亚型
分类
类型
抗原
偶联物
形式
浓度
规格
纯化类型
保存液
内含物
保存条件
运输条件
RRID
产品详细信息
Immunogen sequence: DFLQDYTLLI NILHSEDLGK DVEFEVVGDA PEKVGPKQAE DAAKSITNGS DDGAQPSTST AQEQDDVLIV DSDEEDSSNN AD
Highest antigen sequence indentity to the following orthologs: Rat - 92%, Mouse - 93%.
靶标信息
UBA2 is involved in covalent attachment of one protein to another is one of the more prominent posttranslational modifications in respect to size and ubiquity. Ubiquitin is the most familiar of the protein modifiers and its activation and transfer to target proteins has been studied extensively. Recently, a new group of ubiquitin-like proteins has been receiving a lot of attention. SUMO, or Sentrin, is one of the most intriguing. SUMO has been implicated in the stabilization of target proteins and/or their localization to sub-cellular complexes.The conjugation of SUMO-1, SUMO-2 and SUMO-3 onto target proteins requires the concerted action of the specific E1-activating enzyme SAE1/SAE2, the E2-conjugating enzyme Ubc9, and an E3-like SUMO ligase.
仅用于科研。不用于诊断过程。未经明确授权不得转售。
篇参考文献 (0)
生物信息学
蛋白别名: Anthracycline-associated resistance ARX; FLJ13058; HRIHFB2115; similar to Saccharomyces cerevisiae UBA2; SUMO-1 activating enzyme subunit 2; SUMO-activating enzyme subunit 2; SUMO1 activating enzyme subunit 2; UBA2; UBA2, ubiquitin-activating enzyme E1 homolog; Ubiquitin-like 1-activating enzyme E1B; Ubiquitin-like modifier-activating enzyme 2; unnamed protein product
基因别名: ACCES; ARX; HRIHFB2115; SAE2; UBA2; UBLE1B
UniProt ID: (Human) Q9UBT2
Entrez Gene ID: (Human) 10054